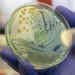
Superbactéria que representa risco de saúde global é detectada no Nordeste

Pesquisadores desenvolveram uma forma de produzir creatina através do cultivo de uma planta. A estratégia pode ser uma forma de aumentar a produção do suplemento esportivo feito com a substância, além de torná-lo uma opção vegana para quem não consome produtos de origem animal. As descobertas foram publicadas no Journal of Agricultural and Food Chemistry, da Sociedade Americana de Química, na última quarta-feira (2).
A creatina é um dos suplementos alimentares mais populares entre atletas e praticantes de musculação. Isso porque a substância é conhecida por seus benefícios para o aumento de força e ganho de massa muscular, além de potencializar a resistência e a performance física durante os treinos.
O nutriente pode ser encontrado naturalmente no organismo, mas também pode ser obtido através de alimentos como carne vermelha, peixe e frango. Porém, no novo experimento, pesquisadores da Universidade de Zhejiang, em Hangzhou, na China, utilizaram módulos sintéticos para produzir creatina em uma planta.
Os módulos sintéticos continham instruções de DNA para codificar enzimas que transformam aminoácidos em creatina. Os cientistas inseriram esses módulos na Nicotiana benthamiana, uma planta semelhante ao tabaco usada como organismo modelo em aplicações de biologia sintética. Segundo o estudo, o módulo resultou em 2,3 microgramas de creatina por grama de material vegetal após três dias.
Os pesquisadores repetiram o experimento com outros dois módulos sintéticos: um com instruções de DNA para codificar enzimas para carnosina, que também é suplemento alimentar popular para exercícios, e outro para codificar taurina, aminoácido utilizado em suplementos para pré-treino e bebidas energéticas.
De acordo com o estudo, a produção de carnosina aumentou em 3,8 vezes, gerando um 18,3 microgramas por grama de folha, em média. Por outro lado, a produção de taurina foi reduzida.
Para os pesquisadores, o trabalho demonstra uma estrutura eficaz para produzir nutrientes complexos tipicamente encontrados em animais em um sistema vegetal vivo. Os cientistas acreditam que trabalhos futuros possam aplicar este método a plantas comestíveis, incluindo frutas e vegetais, ou outras plantas que podem atuar como biofábricas para produzir esses nutrientes de forma sustentável.